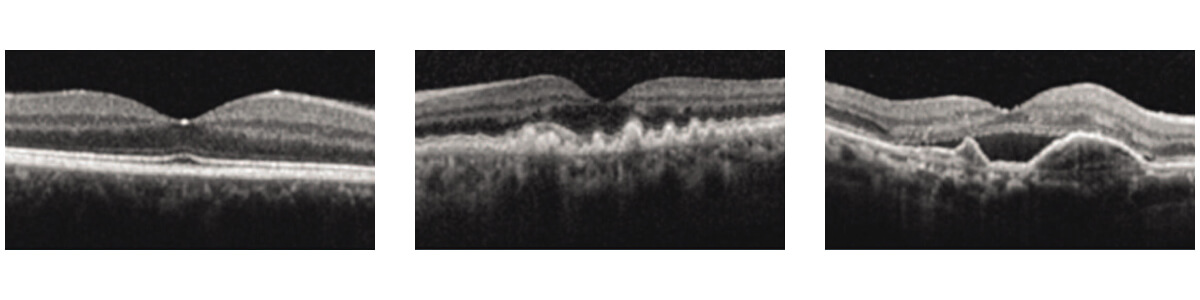

What is Age-Related Macular Degeneration?
Age-related macular degeneration (ARMD or AMD) is the most common cause of irreversible vision loss in the United States, affecting up to 20 percent of people over the age of 60. It is one of the most common conditions that our board-certified retina specialists treat on a daily basis.
AMD is caused by the deterioration of the macula, which is the central area of the retina. This condition causes a loss of central vision that occurs slowly over time. At Retina Consultants of Texas, we work in partnership with each patient to create a customized treatment plan to help slow or stop the progression of the disease.
Macular Degeneration Videos
Types and Symptoms of AMD
AMD usually appears after age 50, and the disease is often bilateral (occurring in both eyes). In addition, patients generally have a significant family history of the disease. Patients with AMD may notice a worsening of their central vision while retaining good peripheral vision. Symptoms of AMD can include:
- Visual distortion, including warping or bending of straight lines and objects
- Blurred central vision in one or both eyes
- Difficulty with reading or close-up work
- Increasing difficulty adapting to changing light conditions, especially low light levels
There are two kinds of age-related macular degeneration (AMD): dry and wet. Both forms can lead to vision loss, and patients can have either or both.
Dry AMD
More than 90% of patients diagnosed with AMD have the dry form, which is often associated with a slower progression of the disease that occurs over many years. It is characterized by drusen formation (yellow deposits under the retina that are made up of lipids, a fatty protein), retinal degeneration, and a gradual wearing away of the retina called atrophy. If these areas of retinal degeneration group together into larger areas, it is called geographic atrophy which is a more advanced stage of the disease. Most patients with early dry AMD with mild retinal changes will have no or minimal problems with their vision. However, in its most advanced form, dry AMD can cause profound central vision loss, often with preserved peripheral (side) vision.
Learn More About Dry AMD / Geographic Atrophy
Dry AMD / Geographic Atrophy (PDF)
Wet AMD
This form of AMD is characterized by the development of abnormal blood vessels known as choroidal neovascular membranes (CNVM) that disrupt the retina and cause leakage of fluid. This growth of abnormal blood vessels can result in vision loss due to fluid build-up in the retina (macular edema), bleeding in the retina, and scar tissue formation (fibrosis). Wet AMD is generally associated with more rapid visual loss over days to weeks compared to the slower progression of dry AMD.
Known Causes
Age-related macular degeneration (AMD) usually occurs after age 50 and is often bilateral (present in both eyes). While the exact cause is unknown, genetics play a role, especially genes related to the control of inflammation[1] (Telander 2011). Many patients have a significant family history of AMD. In addition, numerous studies have revealed that nutritional and lifestyle factors play a role in both the onset and progression of macular degeneration, including:
- Obesity
- Poor diet (especially high levels of saturated fat)
- High blood pressure and cholesterol levels
- Smoking cigarettes
- Cardiovascular disease
Diagnosis
Regular eye examinations are important to diagnose and manage AMD[2] (Ho et al. 2017). While being evaluated by your eye doctor, you may undergo multiple types of ocular imaging, including photography, ocular coherence tomography (OCT), and fluorescein angiography (FA) to help with your diagnosis and specific treatment plan.
Ocular coherence tomography (OCT)
This is a non-invasive ophthalmology imaging method that uses light to capture high-resolution, 3D images of the back of the eye. It allows your retina specialist to see the back of the retina and understand what is taking place.
Fluorescein angiography (FA)
This is an imaging study of the blood supply to the retina. Fluorescein dye is injected into the vein of an arm, and this yellow dye passes through the blood vessels in your retina. A specialized camera is then used to take digital photographs of the blood vessels.
Because age-related macular degeneration can be hereditary, adult relatives of AMD patients should see a retina specialist for a baseline evaluation and dilated eye exam.

Left to right: Normal macula, Dry AMD with drusen, and central geographic atrophy, Wet AMD with bleeding and scar tissue
Left to right: Normal macula OCT, Dry AMD OCT showing drusen, Wet AMD OCT showing fluid under the retina and RPE

Left to right: Normal FA, Dry AMD (autofluorescence) showing central geographic atrophy, Wet AMD FA showing active CNVM centrally with dye leakage into the retina
Treatment and Prognosis
There is currently no cure for either dry or wet AMD. However, there are a number of things you can do to slow the progression of the disease.
Smoking is toxic to the retina and can contribute to AMD progression[3] (Chang et al. 2008). If you smoke, stop smoking as soon as possible! Other ways to optimize your retinal health include eating a healthy diet with regular vegetables and fruits, and maintaining a healthy body weight.
The risk of vision loss from some forms of AMD can be reduced by taking a special combination of supplements. The Age-Related Eye Diseases Studies (AREDS & AREDS2), which were large clinical trials, demonstrated a decreased risk of visual loss from moderate dry AMD by taking a combination of the following:
- 15 mg of Beta-carotene
- 400IU of Vitamin E
- 500 mg of Vitamin C
- 80 mg of Zinc
- 2 mg of copper
- Lutein/Zeaxanthin
In addition, an Amsler grid is a chart to use at home to help monitor your vision. Use it daily for each eye as directed and if you notice changes in your vision, contact your ophthalmologist as soon as possible.
Currently, there are no prescription or surgical treatment options available for slowing or reversing the vision loss caused by dry AMD, but research is ongoing and promising therapies are on the horizon[4] (Jaffe et al. 2021). Incredible advances in our ability to treat wet AMD since the early 2000s have revolutionized patient outcomes. Before that time, a diagnosis of wet AMD carried a very poor prognosis with most eyes progressing to severe vision loss. Fortunately, medications now available can benefit over 90% of wet AMD patients. These medications primarily target VEGF (vascular endothelial growth factor), a molecule responsible for the abnormal blood vessels which cause damage in wet AMD.
Repeated injections of anti-VEGF agents (Avastin, Lucentis & Eylea) have been firmly established as the optimal treatment for wet AMD[5] (Chang et al. 2010). These powerful drugs are given as injections into the eye to suppress abnormal blood vessel growth and leakage. Because these injections are not a cure, but only a treatment, they have to be administered repeatedly (sometimes as often as monthly, indefinitely) in order to have their maximal vision-improving results. Extensive numbing of the eye makes this injection procedure virtually painless. New research is constantly being conducted to find new and improved ways of inhibiting neovascularization using anti-VEGF therapies, paving the way for potential future treatments for wet AMD[6] (Dugel et al. 2020)
If you have AMD, you should:
- Stop smoking.
- See your retina specialist regularly.
- Consider AREDS supplements.
- Check your Amsler grid daily.
- Eat a healthy diet with plenty of vegetables and fish.
- Maintain a healthy body weight.
Learn More About Age-Related Macular Degeneration
Age-Related Macular Degeneration (PDF)
- Telander DG. Inflammation and age-related macular degeneration (AMD). Semin Ophthalmol. 2011 May;26(3):192-7. pubmed.ncbi.nlm.nih.gov/21609232
- Ho AC, Albini TA, Brown DM, Boyer DS, Regillo CD, Heier JS. The Potential Importance of Detection of Neovascular Age-Related Macular Degeneration When Visual Acuity Is Relatively Good. JAMA Ophthalmol. 2017 Mar 1;135(3):268-273. pubmed.ncbi.nlm.nih.gov/28114653
- Chang MA, Bressler SB, Munoz B, West SK. Racial differences and other risk factors for incidence and progression of age-related macular degeneration: Salisbury Eye Evaluation (SEE) Project. Invest Ophthalmol Vis Sci. 2008 Jun;49(6):2395-402. pubmed.ncbi.nlm.nih.gov/18263809
- Jaffe GJ, Westby K, Csaky KG, Monés J, Pearlman JA, Patel SS, Joondeph BC, Randolph J, Masonson H, Rezaei KA. C5 Inhibitor Avacincaptad Pegol for Geographic Atrophy Due to Age-Related Macular Degeneration: A Randomized Pivotal Phase 2/3 Trial. Ophthalmology. 2021 Apr;128(4):576-586.
- Chang MA, Do DV, Bressler SB, Cassard SD, Gower EW, Bressler NM. Prospective One-Year Study of Ranibizumab for Predominantly Hemorrhagic Choroidal Neovascular Lesions in Age-Related Macular Degeneration, Retina: September 2010;30(8):1171-1176. journals.lww.com/retinajournal/Abstract/2010/09000
- Dugel PU, Boyer DS, Antoszyk AN, Steinle NC, Varenhorst MP, Pearlman JA, Gillies MC, Finger RP, Baldwin ME, Leitch IM. Phase 1 Study of OPT-302 Inhibition of Vascular Endothelial Growth Factors C and D for Neovascular Age-Related Macular Degeneration. Ophthalmol Retina. 2020 Mar;4(3):250-263. pubmed.ncbi.nlm.nih.gov/31924544
Visit Retina Consultants of Texas for Age-Related Macular Degeneration Treatment in Houston and San Antonio
At Retina Consultants of Texas, preserving your vision is our mission. We offer a full spectrum of retinal care using the most advanced technologies to address diseases of the retina, macula, and vitreous. For world-class retinal care, including age-related macular degeneration treatment, schedule an appointment with RCTX in the Greater Houston and Greater San Antonio, TX areas today.

